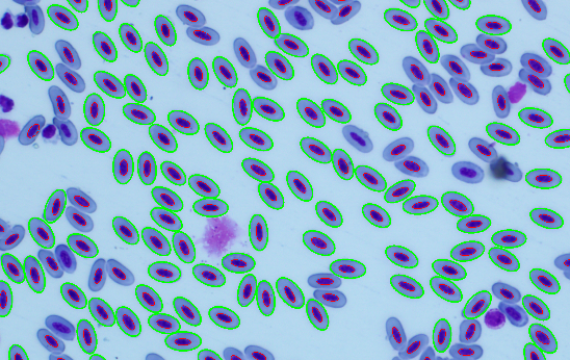
Detection of Avian Red Blood Cells

THESIS SUPERVISORS
Our extensive experience in thesis supervision will help you
The Department of Image Information Processing of the Institute of Image Processing of the CAS supervises bachelor and master theses of students of the MFF UK and FJFI CTU. If you are interested in any of the theses, please send an e-mail directly to the thesis sponsor or to zitova@utia.cas.cz. The above topics can be worked on both bachelor and diploma level. If you have your own idea that you would like to work on as part of your bachelor's or master's thesis, you can also contact us, we will certainly make arrangements.
Topics will be gradually added by their supervisors.

OUR OFFER OF THESIS TOPICS

Segmentation of 2D Diffraction Patterns in 4D Scanning Transmission Electron Microscopy Using Deep Learning
Electron microscopy is one of the key analytical methods for studying the structure of crystalline m...
Read More
Machine Learning for Dynamic Inverse Problems in Microscopy
Join a cutting-edge research project at the crossroads of computer vision, deep learning, and cell b...
Read More
Detection of Avian Red Blood Cells
Abstract: The aim of this thesis is to develop and implement a method for the detection of avian red...
Read More
Finding the limits of detection algorithms
Abstract: Nowadays, detection algorithms based on neural networks work with high detection accuracy....
Read More
Probabilistic representation of spatial fuzzy sets
Abstract: Fuzzy sets theory is usually applied to represent uncertain, vague objects that cannot be ...
Read More
Object recognition in historical maps
Abstract: Historical maps depict important landmarks, such as river networks or dwellings, however, ...
Read More
Remote sensing from aerial photography
Abstract: High-resolution aerial images are commonly available. Within this topic, several theses ar...
Read More
Recognition of rotated 3D scans
Abstract: The task is recognition of data from 3D scanner. It yields the triangulated surface and 2D...
Read More
AI in art analysis
Abstract: The thesis deals with the use of artificial intelligence in the analysis and restoration o...
Read More
Neural-based segmentation of complex particles in environmental electron microscopy
Abstract: In particle analysis, the statistics of various shape variables must be determined, and th...
Read More
Computer vision-enabled intelligent robotic arm system
Abstract: This thesis deals with developing an intelligent robotic arm system enhanced with computer...
Read More
Multimodal data fusion for visualization of applied substances in cells
Abstract: This study introduces a novel approach to visualizing applied substances within cells by l...
Read More
Imaging detection of wound healing
Abstract: This study focuses on the development of an advanced imaging detection system for monitori...
Read More
Continuous space-time video super-resolution
Abstract: The quest for high-quality video content necessitates the advancement of techniques to imp...
Read More
Automatic inspection of assembled parts in the automotive industry
Abstract: Over 10,000 parts need to be assembled in the production process of a car. It's not just a...
Read More


